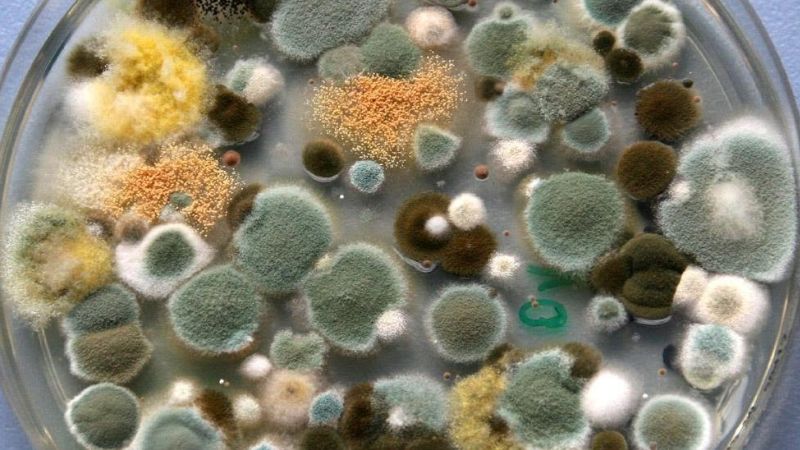
mold growth timeline

Water damage moves fast. Mold moves faster than most people expect.
Within 24 to 48 hours of moisture entering your home, mold spores can begin to germinate. Within a week, you may have visible colonies spreading across drywall, wood, and insulation. The window to act is narrow, and what you do in those first hours determines whether you’re dealing with a cleanup or a full remediation.
The 24–48 Hour Window: Why It Matters
Mold spores are always present in the air around us. Under normal conditions, they’re harmless. But introduce moisture from a burst pipe, storm flooding, or a slow leak — and conditions shift quickly.
The IICRC (Institute of Inspection, Cleaning and Restoration Certification) establishes that mold growth typically begins within 24 to 48 hours of water damage. Several factors influence exactly how fast:
- Temperature: Mold thrives between 77–86°F. Most homes fall right in that range.
- Humidity: Levels above 60% accelerate growth significantly.
- Material type: Porous, organic materials — drywall, wood, carpet, insulation — give mold the nutrients it needs to establish quickly.
- Water source: Contaminated water from sewage backups or flooding introduces additional microorganisms, compounding the risk.
Speed matters here. Every hour of standing moisture is an hour mold has to take hold.
Visible Mold Is Only Part of the Problem
By the time you see black, green, or white patches on a surface (or notice that unmistakable musty odor), mold has almost certainly been growing longer than it appears. Visible surface growth is often the end of a process that started days earlier inside wall cavities, beneath flooring, and in HVAC systems.
Professional moisture detection equipment: thermal imaging cameras, moisture meters, can identify these hidden problem areas before they become structural issues. That’s the difference between catching a problem early and discovering it’s been quietly growing for weeks.
Health Signs You Shouldn’t Ignore
Persistent coughing, sneezing, throat irritation, and worsening allergy symptoms can all indicate mold presence before any visible growth appears. Children, elderly family members, and anyone with a compromised immune system or existing respiratory condition are at heightened risk.
The EPA is clear: mold exposure causes real health consequences. If symptoms are appearing and you’ve recently had water damage, don’t wait for visible confirmation.
When to Call a Professional
Some water damage situations are manageable on your own. Many aren’t.
Professional remediation is the right call when:
- The affected area exceeds 10 square feet
- Sewage or contaminated water was involved
- Structural materials like drywall or subfloor require removal
- Mold has been present for an unknown or extended period
IICRC standards require professional remediation teams to follow strict containment protocols, use HEPA filtration, and properly dispose of contaminated materials — preventing spores from spreading to unaffected areas during cleanup.
This isn’t a job for a bleach spray and good intentions.
What Professional Mold Remediation Actually Looks Like
A thorough remediation isn’t just cleaning what’s visible. It’s finding and eliminating every source.
The process typically includes:
- Assessment: Thermal imaging and moisture mapping to understand the full extent of water penetration and mold development
- Containment: Isolating affected areas to prevent cross-contamination during cleanup
- Air filtration: HEPA systems running throughout the process to capture airborne spores
- Material removal: Contaminated drywall, insulation, or flooring removed and properly disposed of
- Structural drying: Industrial dehumidification equipment removing moisture from building materials — not just the air
- Surface treatment: Cleaning, spore abatement, and application of mold-inhibiting coatings to treated surfaces
Insurcomm’s certified remediation team manages this entire process — from initial water extraction through final restoration — so there are no gaps in service where mold problems quietly develop.
A Note on Insurance Coverage
Most homeowner’s insurance policies cover mold remediation when it stems from a covered water damage event. But coverage limits vary, and delays in reporting or remediation can complicate claims.
Document everything immediately: photographs of all damage, written records of mitigation steps taken, and dates of discovery and response. Working with a restoration company experienced in insurance coordination makes this process significantly smoother.
Frequently Asked Questions
Can mold grow in just 24 hours after water damage? Mold spores can begin germinating within 24 hours under the right conditions. Visible growth typically appears after 48–72 hours, but microscopic growth starts earlier.
Which areas of a home are most at risk? Bathrooms, basements, crawl spaces, and areas with limited ventilation face the highest risk. These locations combine moisture retention with poor air circulation, ideal conditions for rapid mold development.
How long does full remediation take? Moderate cases typically resolve in 3–7 days. Extensive contamination involving structural materials can take several weeks. The earlier remediation begins, the shorter — and less costly — the process. Insurcomm’s team will provide guidance and timelines specific to your situation.
Don’t Give Mold a Head Start
The timeline is unforgiving. Water damage today can become a mold problem by tomorrow — and a structural issue by next week.
Insurcomm’s 24/7 emergency response team combines water damage mitigation with proactive mold prevention, managing the full recovery from first call to final restoration. When every minute counts, you deserve a team that moves with the same urgency you do.
Call Insurcomm at (844) 424-9283 — we’re available 24/7.